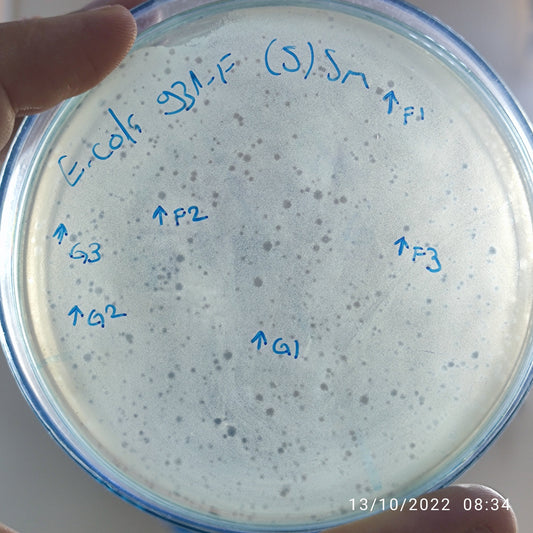
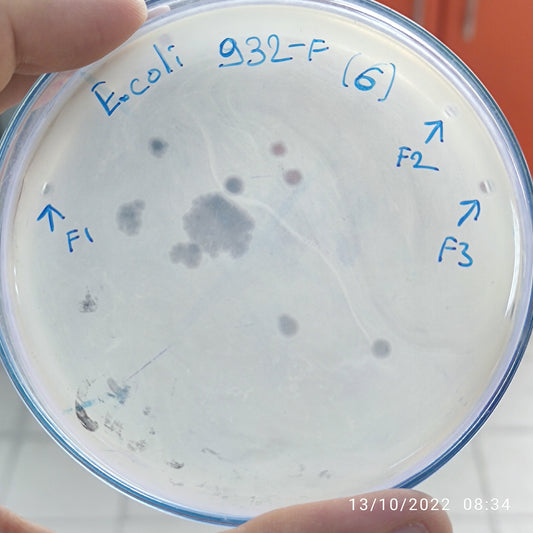
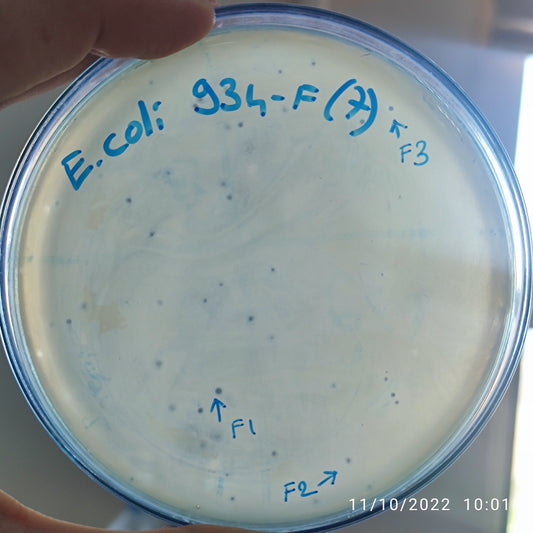
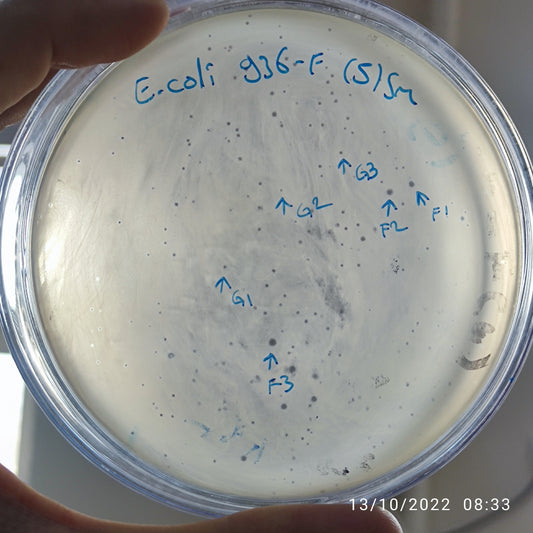
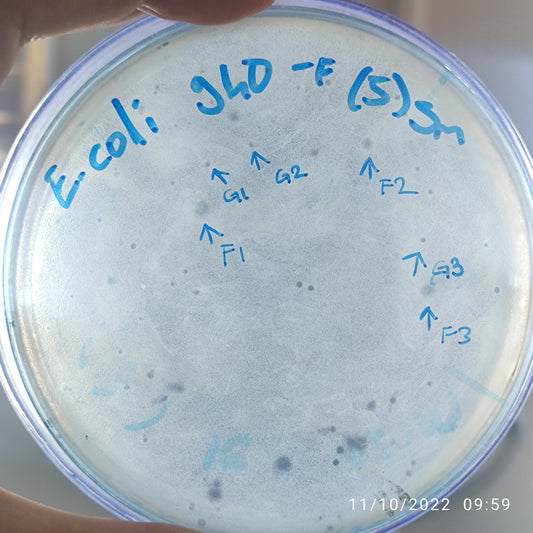
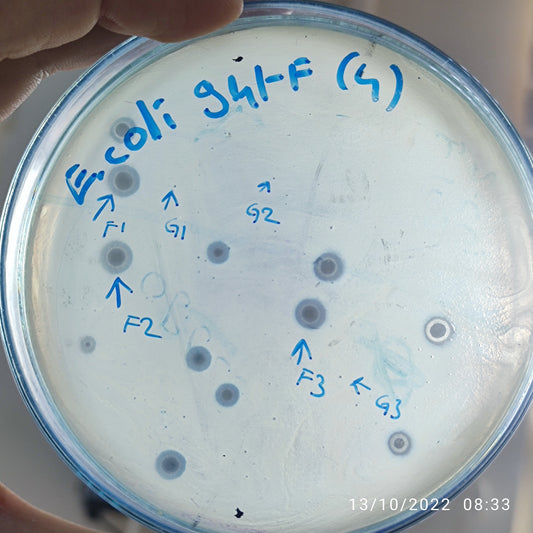
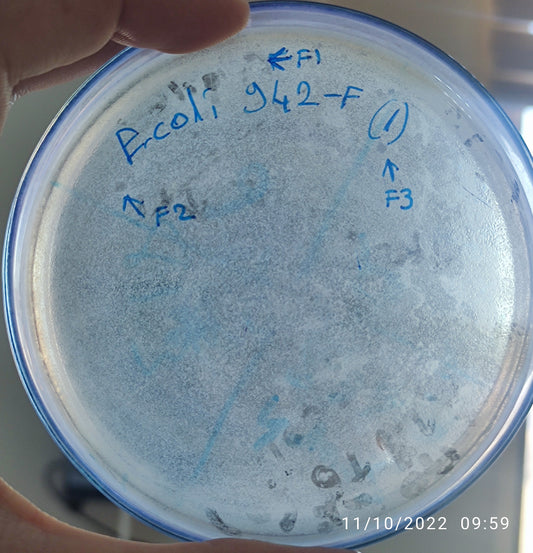

-
Escherichia coli bacteriophage 100931G
Regular price $500.00 USDRegular priceUnit price per -
Escherichia coli bacteriophage 100932F
Regular price $500.00 USDRegular priceUnit price per -
Escherichia coli bacteriophage 100932G
Regular price $500.00 USDRegular priceUnit price per -
Escherichia coli bacteriophage 100933F
Regular price $500.00 USDRegular priceUnit price per -
Escherichia coli bacteriophage 100934F
Regular price $800.00 USDRegular priceUnit price per -
Escherichia coli bacteriophage 100935F
Regular price $750.00 USDRegular priceUnit price per -
Escherichia coli bacteriophage 100936F
Regular price $500.00 USDRegular priceUnit price per -
Escherichia coli bacteriophage 100936G
Regular price $500.00 USDRegular priceUnit price per -
Escherichia coli bacteriophage 100937F
Regular price $500.00 USDRegular priceUnit price per -
Escherichia coli bacteriophage 100939F
Regular price $500.00 USDRegular priceUnit price per -
Escherichia coli bacteriophage 100940F
Regular price $500.00 USDRegular priceUnit price per -
Escherichia coli bacteriophage 100940G
Regular price $500.00 USDRegular priceUnit price per -
Escherichia coli bacteriophage 100941F
Regular price $600.00 USDRegular priceUnit price per -
Escherichia coli bacteriophage 100941G
Regular price $500.00 USDRegular priceUnit price per -
Escherichia coli bacteriophage 100942F
Regular price $500.00 USDRegular priceUnit price per -
Escherichia coli bacteriophage 100944F
Regular price $500.00 USDRegular priceUnit price per